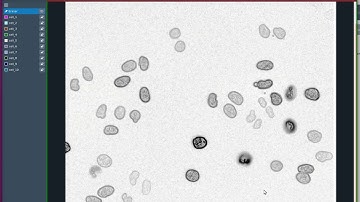

⬇ DOWNLOAD NOW
Kalau muncul iklan pop-up, tutup lalu klik tombol kembali
Download lagu Final Year Projects 2015 | Methods for Nuclei Detection, Segmentation, and Classification secara gratis hanya untuk keperluan promosi. Dukung artis favorit kamu dengan membeli musik original di iTunes atau platform resmi lainnya.
 Final Year Projects 2015 | Methods for Nuclei Detection, Segmentation, and Classification
Final Year Projects 2015 | Methods for Nuclei Detection, Segmentation, and Classification
 Final Year Projects 2015 | Semi-Automatic Segmentation and Classification
Final Year Projects 2015 | Semi-Automatic Segmentation and Classification
Nuclear segmentation 1
Nuclear segmentation 1
 Histo Nuclei & fundus Exudates Segmentation - Modified U-net Model - Own Data
Histo Nuclei & fundus Exudates Segmentation - Modified U-net Model - Own Data
 Image Segmentation-based Unsupervised Multiple Objects Discovery
Image Segmentation-based Unsupervised Multiple Objects Discovery
 Deep Learning Methods for Lung Cancer Segmentation in Whole slide Histopathology Images the ACDC@L
Deep Learning Methods for Lung Cancer Segmentation in Whole slide Histopathology Images the ACDC@L
 ZeroCostDL4Mic Video #4: Stardist to segment nuclei and TrackMate to automatically track migration
ZeroCostDL4Mic Video #4: Stardist to segment nuclei and TrackMate to automatically track migration
 HoVer-Net: Simultaneous Segmentation and Classification of Nuclei
HoVer-Net: Simultaneous Segmentation and Classification of Nuclei